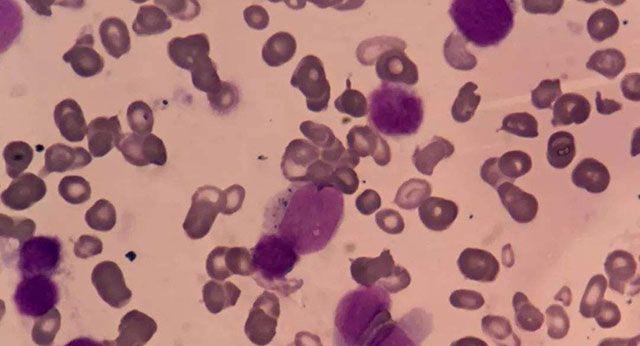

8号染色体异常会怎样?或导致这5种罕见疾病!
- 试管婴儿
- 2023-05-03 08:47
人类通常在每个细胞中有46条染色体,分为23对。8号染色体的两个拷贝,一个从每个亲本遗传的拷贝,形成一对。8号染色体跨越超过1.46亿个DNA构建块(碱基对),占细胞总DNA的4.5%至5%。
8号染色体异常会怎样
识别每条染色体上的基因是遗传研究的一个活跃领域。由于研究人员使用不同的方法来预测每条染色体上的基因数量,因此估计的基因数量会有所不同。8号染色体可能含有约700个基因,这些基因提供了制造蛋白质的说明。这些蛋白质在体内发挥着各种不同的作用。
8号染色体图
遗传学家使用称为idiograms的图表作为染色体的标准表示。图像显示染色体的相对大小及其条带图案,这是当染色体用化学溶液染色然后在显微镜下观察时出现的暗带和亮带的特征图案。这些条带用于描述每条染色体上基因的位置。
8号染色体图表
8号染色体异常相关疾病
1、8p11骨髓增生综合征
8p11骨髓增生综合征是8号染色体和其他染色体之间遗传物质的易位可引起8p11骨髓增生综合征。该病症的特征在于白细胞数量增加(骨髓增生性疾病)和淋巴瘤的发展,淋巴瘤是一种导致淋巴结肿瘤形成的血液相关癌症。骨髓增生性疾病通常发展成另一种称为急性髓性白血病的血癌。这种情况中最常见的易位,写为t(8; 13)(p11; q12),融合了8号染色体上的部分FGFR1基因与13号染色体上的部分ZMYM2基因。仅在癌细胞中发现了易位。
8p11骨髓增生综合征
由正常FGFR1基因产生的蛋白质可以打开(激活)细胞信号传导,其帮助细胞响应其环境,例如通过刺激细胞生长。无论所涉及的伴侣基因如何,由融合基因产生的蛋白质导致恒定的FGFR1信号传导。不受控制的信号传导促进细胞持续生长和分裂,导致癌症。
2、核心结合因子急性髓性白血病(CBF-AML)
核心结合因子急性髓性白血病(CBF-AML)是一种核心结合因子急性髓性白血病(CBF-AML)的血癌与8号和21号染色体之间遗传物质的重排(易位)有关。这种重排与成人急性髓性白血病病例的约7%相关。移位,写为t(8; 21),融合了来自8号染色体的部分RUNX1T1基因(也称为ETO)和部分来自21号染色体的RUNX1基因。这种突变是在一个人的一生中获得的,仅存在于某些细胞。这种称为体细胞突变的遗传变异不是遗传的。
核心结合因子急性髓性白血病
由T(8; 21)易位产生的融合蛋白,称为RUNX1-ETO,保留了两种单个蛋白质的一些功能。由RUNX1基因产生的正常RUNX1蛋白是称为核心结合因子(CBF)的蛋白质复合物的一部分,其附着(结合)DNA并激活参与血细胞发育的基因。正常的ETO蛋白,由RUNX1T1产生基因,关闭(抑制)基因活动。融合蛋白形成CBF并附着在DNA上,但它不是激活刺激血细胞发育的基因,而是抑制这些基因。基因活性的这种变化阻碍了血细胞的成熟(分化),并导致产生称为骨髓母细胞的异常,未成熟的白细胞。虽然t(8; 21)对于白血病发展很重要,但是骨髓母细胞通常需要一种或多种额外的遗传变化才能发展成癌性白血病细胞。
3、重组8综合征
该病症涉及心脏和泌尿道异常,中度至重度智力残疾和独特的面部外观。这种重新排列导致一条短(p)臂的缺失和一条长(q)臂的重复。该染色体异常写成rec(8)dup(8q)inv(8)(p23.1q22.1)。重组8综合征的体征和症状与8号染色体短臂遗传物质的丢失以及8号染色体长臂上存在额外的遗传物质有关。研究人员正在努力确定哪些基因与删除有关。和8号染色体上的重复。
重组8综合征
4、Trichorhinophalangeal综合II型(TRPS II)
Trichorhinophalangeal综合II型(TRPS II)是由8号染色体的长(q)臂上的遗传物质的缺失引起的.TRPS II是引起骨和关节畸形的病症; 独特的面部特征; 智力残疾; 和皮肤,头发,牙齿,汗腺和指甲的异常。TRPS II的体征和症状与染色体这一部分的多个基因的丢失有关。删除的大小因受影响的个体而异; 研究表明,较大的缺失往往导致比较小的缺失更多的特征。
Trichorhinophalangeal综合II型(TRPS II)
该TRPS1,EXT1,和RAD21基因缺失在人与TRPS II。研究人员已经确定,EXT1基因的缺失是造成TRPS II患者的多种良性(非癌)骨肿瘤的原因,称为骨软骨瘤。该损失TRPS1基因被认为是导致其他骨骼和面部畸形。删除RAD21基因可能会导致智力残疾。来自8号染色体区域的其他基因的丢失可能有助于这种情况的额外特征。
5、其他癌症
8号染色体和其他染色体之间的易位与其他类型的癌症有关。例如,伯基特淋巴瘤(一种称为B细胞的白细胞癌,最常见于儿童和年轻人,可能是由8号染色体和14之间的易位引起的。这种易位,写成t(8; 14)(q24; q32),导致无控制或有序的连续细胞分裂,这可能有助于伯基特淋巴瘤的发展。不太常见的是,Burkitt淋巴瘤可由8号染色体和2或8号染色体和22之间的易位引起。
8号染色体易位或daozh
当细胞具有8号染色体的三个拷贝而不是通常的两个拷贝时,发生三体**。当体内所有细胞都含有8号染色体的额外拷贝时,完整的三体**与生命不相容。当只有一些身体的细胞有8号染色体的额外拷贝时,发生类似但不太严重的称为马赛克三体**的病症。马赛克三体**的体征和症状差异很大,可能包括智力残疾,缺乏连接左侧和左侧的组织。右半部分(胼call体),骨骼缺陷,心脏问题,肾脏和肝脏畸形,以及面部异常。8三体镶嵌现象也与急性髓性白血病的风险增加有关。
另一种称为反转复制8p的染色体状况是由8号染色体的短(p)臂上的遗传物质的重排引起的。这种重排导致异常复制和染色体片段的倒位。反演涉及两个地方的染色体断裂; 将得到的DNA片段翻转并重新插入染色体。具有倒置复制8p的人通常具有严重的智力残疾,胼call体薄或缺乏,肌张力弱(张力减退),脊柱弯曲异常(脊柱侧凸)和轻微的面部异常。患有这种疾病的一些人也可能有心脏缺陷,肾脏发育不全或眼睛异常。年龄较大的人通常会出现异常的肌肉僵硬(痉挛状态)。反转重复8p的体征和症状倾向于取决于所涉及的染色体区段的大小和位置。例如,认为包含染色体区域8p21与更严重的症状相关。

发表评论